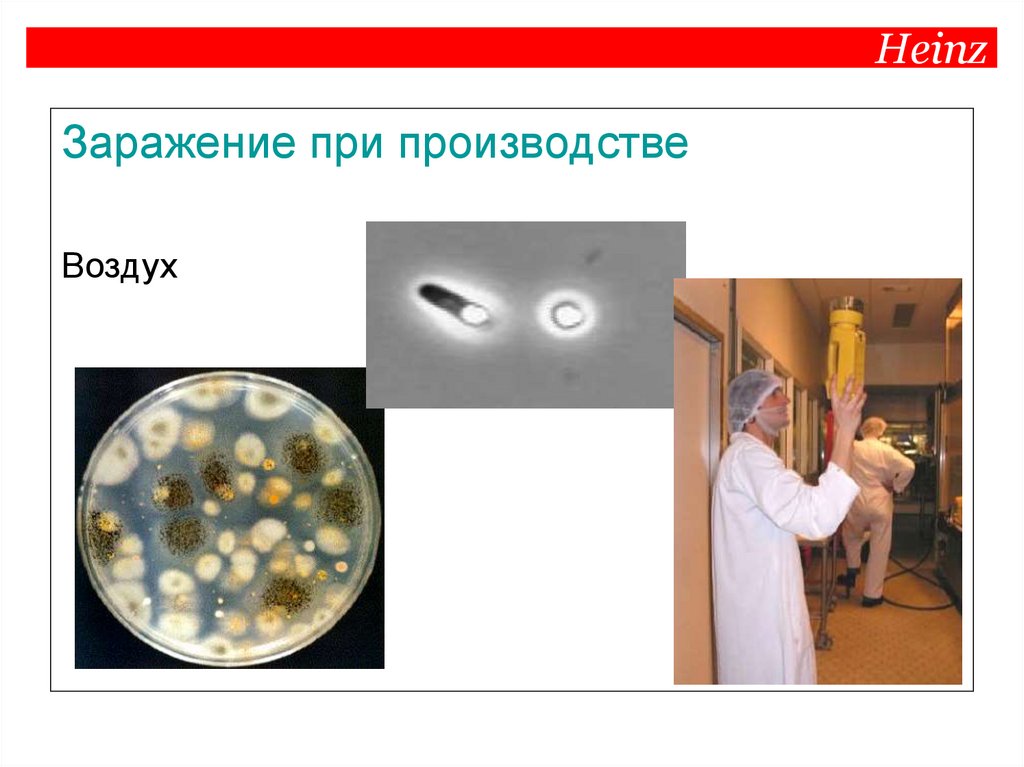
Heinz

Похожие презентации:
Микробиология
1. Heinz
MASTER OF SANITATIONМикробиология
2. Heinz
Микробиология• Микроорганизмы
• Загрязнение и рост
• Дезинфекция
• Предотвращение возникновения
проблем
3. Heinz
Микроорганизмы могут быть полезными4. Heinz
Но могут вызвать порчу !!5. Heinz
Пища - причина пищевых отравленийВ ОСНОВНОМ ПРОДУКТЫ ЖИВОТНОГО ПРОИСХОЖДЕНИЯ:
мясо, домашняя птица, сырое молоко, яйца, морепродукты
НО ТАКЖЕ ВСЕ ЧАЩЕ: ФРУКТЫ И ОВОЩИ !!
6. Heinz
Микроорганизмы в продуктеБактерии - палочки
7. Heinz
Бактерии – споровые формыBacillus
Clostridium
споры очень устойчивы к
внешним факторам…
8. Heinz
Микроорганизмы в пищевых продуктахДрожжи
9. Heinz
Микроорганизмы в пищевых продуктахПлесени
10. Heinz
Рост дрожжейПочкование
11. Heinz
Рост плесениСпорообразование
12. Heinz
Заражение при переработкеПерсонал
Воздух
Оборудование
Вода
Вредители
Упаковка
13. Heinz
Заражение при производствеПерсонал
14. Heinz
Заражение при производствеВоздух
15. Heinz
Заражение при производствеОборудование
- коррозия
- негигиенический дизайн
- повторное загрязнение (вода..)
- биопленка
16. Heinz
Загрязнение водой17. Heinz
Вредители и паразиты18. Heinz
Упаковка19. Heinz
Мойка и дезинфекция- Удаление остатков продукта и загрязнений
- Уменьшение количества МО до приемлемого уровня
1. Удаление крупных остатков/осадков
2. Предварительное ополаскивание
3. Мойка
4. Ополаскивание чистой водой
5. Дезинфекция
6. Финальное ополаскивание (сушка)
20. Heinz
Мойка перед дезинфекциейОстатки продукта в оборудовании это…
- Защита для микроорганизмов (адаптация)
- Питательная среда для микроорганизмов
- Снижение эффективности дезинфектанта
- Снижение эффективности оборудования (н-р, теплообменников)
21. Heinz
Антибактериальный эффект дезинфекцииЦелью является поражение множества клеток быстрое уничтожение (снижение лог-показателя)
Высокая концентрация (как бывает на практике) –
приводит к подавлению активности клетки
Низкая, тормозящая рост концентрация –
торможение роста, может привести к возникновению
устойчивых штаммов МО.
22. Heinz
Тщательная мойка, предотвращение проливов23. Heinz
НУЖНО ПОМНИТЬ ….1.
Микроорганизмы есть везде и всегда
2.
Мы должны, по возможности, предотвращать
загрязнения (мойки, уборки, дезинфекция,
гигиена)
3.
Мы всегда готовы к предотвращению роста МО
24. Heinz
Безопасность продуктазависит от нас всех
Подходите с той же внимательностью и заботой к
поддержанию в порядке своего рабочего места, с
какой вы готовите собственную еду для того,
чтобы предотвратить…

Биология
Биология БЖД
БЖД








